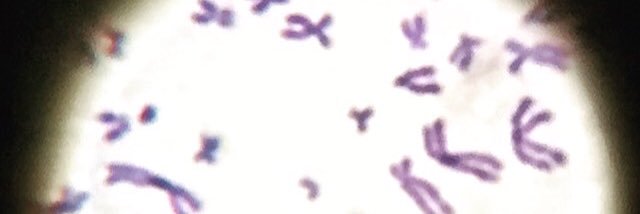
Rebecca LeBard banner

Some holiday writing: My dog keeps taking me for coffee...
medium.com/p/my-dog-took-…
English
Rebecca LeBard
12.8K posts

@rlebard
Scientist BSc (hons) PhD👩🏽🔬 | Educator MEd (HE) SFHEA 👩🏽🎓 | 🔬🧫🧬| #biology #microbiology #biochemistry #higherEd | #running







Join us for the biannual Goldsworthy Memorial Lecture and 3-course sit down dinner. Dr Jocelyne Basseal @JocelyneBasseal from University of Sydney is presenting the 2024 Goldsworthy Memorial Lecture. Held 19th Sept 2024 6:30 PM in Sydney Sign up: trybooking.com/events/landing…













